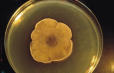

Alternaria
"Macrosporium, Stemphylium, Pseudostemphylium"

Introduction
The large spore size 20 - 200 microns in length and 7 - 18 microns in sizes, suggests that the spores from this fungi will deposited in the nose, mouth and upper respiratory tract (more information below).
Specimens of Alternaria are often found growing on carpets, textiles and horizontal surfaces such as window frames. It is commonly found in soil, seeds and plants. It is known to be a common allergen. It appears as a velvety tuft with long soft hairs and its color ranges from dark olive green to brown. Alternaria is a dry spore and is readily found in air samples as well as on tape lift samples. Alternaria is commonly found in water damaged buildings, and a significant increase in its numbers compared to outdoor levels can be a sign of growth.
Conidia dimensions is about 18-83 x 7-18. Large spore size 20-200 x 7-18 suggest that the spores from this fungi will be deposited in the nose, mouth, gut, and upper respiratory tract.
Commonly found in outdoor air, on many kinds of plants and food products and prefers rotting farmland manure. It may be resistant to fungicides. Alternaria is considered an occasional contaminant of water damaged building materials which contain cellulose. Although Alternaria is a notable source of fungal allergy, pathogenic infections are also reported infrequently.
Toxin Production and clinical information
Toxins: Alternaria has a unique group of mycotoxins, including alternariols, altenuenes, altertoxins, tenuazonic acid, and AAL toxins. Alternariols and altenuenes are weakly toxic to mice and are cytotoxic (toxic to cultured human cell lines) in vitro at concentrations between 6 and 28 ug/ml (15). Altertoxins and the related compound stemphyltoxin-III, also produced by Alternaria, are mutagenic. Tenuazonic acid (Chemical name: 2H-Pyrrol-2-one, 3-acetyl-1,5-dihydro-4-hydroxy-5-(1-methylpropyl)-, (S-(R*,R*))-) appears to inhibit protein synthesis by preventing newly formed protein molecules from detaching from the ribosomes on which they formed.
It is lethally toxic to young birds, and in administration to animals produced effects such as "salivation, emesis (vomiting), anorexia (avoidance of eating), erythema (red skin flush), gastrointestinal hemorrhage, convulsions, increase in packed cell volume (an immune parameter) and many other effects" (see symptoms). AAL toxins appear to have limited toxic effects against some cultured mammalian cell lines, but are mainly of significance in invasions of plants by Alternaria phytopathogens.
Alternaria has been associated in some cases of hypersensitivity Pneumonitis. Often found in carpets, textiles, and on horizontal surfaces and building interiors. Also, it has been often discovered in damp places, basements, soil, seed, and plants. Outdoors, it may be isolated from samples of soil, seeds and plants.
It has been shown to be related to bakers asthma. It has also been associated with hypersensitivity pneumonitis; Common cause of extrinsic asthma (immediate-type hypersensitivity: type 1).
Acute symptoms include edema and bronchi spasms, chronic cases may develop pulmonary emphysema. As with other toxigenic molds, alternaria can also alter DNA, as well as weaken the human immune system.
Alternaria and the Environment
Alternaria radicina, A. carotiincultae, and A. petroselini are closely related pathogens of umbelliferous crops. Relationships among these fungi were determined based on growth rate, spore morphology, cultural characteristics, toxin production, and host range. Random amplified polymorphic DNA (RAPD) analysis of these species, other species of Alternaria, and closely related fungi was also performed. A. petroselini was readily differentiated from A. radicina and A. carotiincultae on the basis of spore morphology, production of microsclerotia, host range, and RAPD analysis.
Alternaria radicina and A. carotiincultae were considerably more similar to each other than to A. petroselini, but could be differentiated on the basis of growth rate, spore morphology, colony morphology, and, to a limited extent, RAPD analysis.
When grown on media having a high nutritional content, A. radicina produced a diffusible yellow pigment and crystals of the fungal metabolite radicinin. In contrast, A. carotiincultae produced little or no radicinin. However, when A. carotiincultae was grown on the same medium amended with radicinin, growth rate and colony and conidial morphology were more similar to those of A. radicina. These results suggest that the morphological differences between A. radicina and A. carotiincultae are due, at least in part, to radicinin production, and that these fungi are conspecific. Therefore, we propose that A. carotiincultae be considered a synonym of A. radicina.
For treatment, symptoms, and medical information, see
BACK for more fungal descriptions and images
Additional Reading
Aldridge DC, Grove JF., 1964 Metabolic products of Stemphylium radicinum. Part II. (-)-7-hydroxy-4-oxo-oct-2-enoic acid lactone J Chem Soc3239-3241
Commonwealth Agricultural Bureau (CAB). 1972 CMI index descriptions of pathogenic fungi and bacteria No. 346 Commonwealth Mycol. Inst., Kew
Grogan RG, Snyder WC., 1952 The occurrence and pathological effects of Stemphylium radicinum on carrots in California Phytopathology 42:215-218
Grove JF., 1964 Metabolic products of Stemphylium radicinum. Part I. Radicinin J Chem Soc 3234
Grove JF., 1970 Metabolic products of Stemphylium radicinum. Part III. Biosynthesis of radicinin and pyrenophorin J Chem Soc (C) 1860
Joly P., 1964 Le Genre Alternaria Encycl Mycol 33:1-250
Lauritzen JI., 1926 The relation of black rot to the storage of carrots J Agric Res 33:1025-1041
Maude RB., 1966 Studies on the etiology of black rot, Stemphylium radicinum (Meier, Drechsl., & Eddy) Neerg., and leaf blight, Alternaria dauci (Kuhn) Groves & Skolko, on carrot crops; and on fungicide control of their seed-borne infection phases Ann Appl Biol 57:83-93
Meier FC, Drechsler C, Eddy ED., 1922 Black rot of carrots caused by Alternaria radicina N. Sp Phytopathology 12:157-168
Nakajima H, Ishida T, Otsuda Y, Hamasaki T, Ichinoe M., 1997 Phytotoxins and related metabolites produced by Bipolaris coicis, the pathogen of Job's Tears Phytochemistry 45:41-45
Neergaard P., 1945 Danish Species of Alternaria and Stemphylium London: Oxford University Press. 560 p
Noordeloos ME, Gruyter J De, Eijl GW Van, Roeijmans HJ., 1993 Production of dendritic crystals in pure cultures of Phoma and Ascochyta and its value as a taxonomic character relative to morphology, pathology and cultural characteristics Mycol Res 97:1343-1350
Nukina M, Marumo S., 1977 Radicinol, a new metabolite of Cochliobolus lunata, and absolute stereochemistry of radicinin Tetrahedron Letters 37:3271-3272
Pryor BM, Davis RM, Gilbertson RL., 1997 Morphological and molecular characterization of Alternaria radicina, a review of the species Inoculum 48:3. (Abstract)
Pryor BM, Gilbertson RL., 2000 Molecular phylogenetic relationships amongst Alternaria species and related fungi based upon analysis of nuclear ITS and mt SSU rDNA sequences Mycol Res 104:1312-1321
Robeson DJ, Gray GR, Strobel GA., 1982 Production of the phytotoxins radicinin and radicinol by Alternaria chrysanthemi Phytochemistry 21:2359-2362
Sambrook J, Fritsch EF, Maniatis T., 1989 Molecular cloning: a laboratory manual (3) Cold Spring Harbor: Cold Spring Harbor Laboratory Press. 316 p
Simmons EG., 1992 Alternaria taxonomy: current status, viewpoint, challenge In: Chelkowski J, Visconti A, eds. Alternaria Biology, Plant Diseases and Metabolites. Amsterdam: Elsevier Science Publishers BV. 573 p
Simmons EG., 1995 Alternaria themes and variations (122–144) Mycotaxon 55:55-163
Tahvonen R., 1978 Seed-borne fungi on parsley and carrot; Alternaria dauci, Stemphylium radicinum, Septoria petroselini J Sci Agric Soc Finl 50:91-102
Tsuneda A, Skoropad WP., 1977 Formation of microsclerotia and chlamydospores from conidia of Alternaria brassicae Can J Bot 55:1276-1281
Wearing AH., 1980 Alternaria radicina on celery in South Australia APP Aust Plant Pathol Melbourne: Australian Plant Pathology Society 9:116